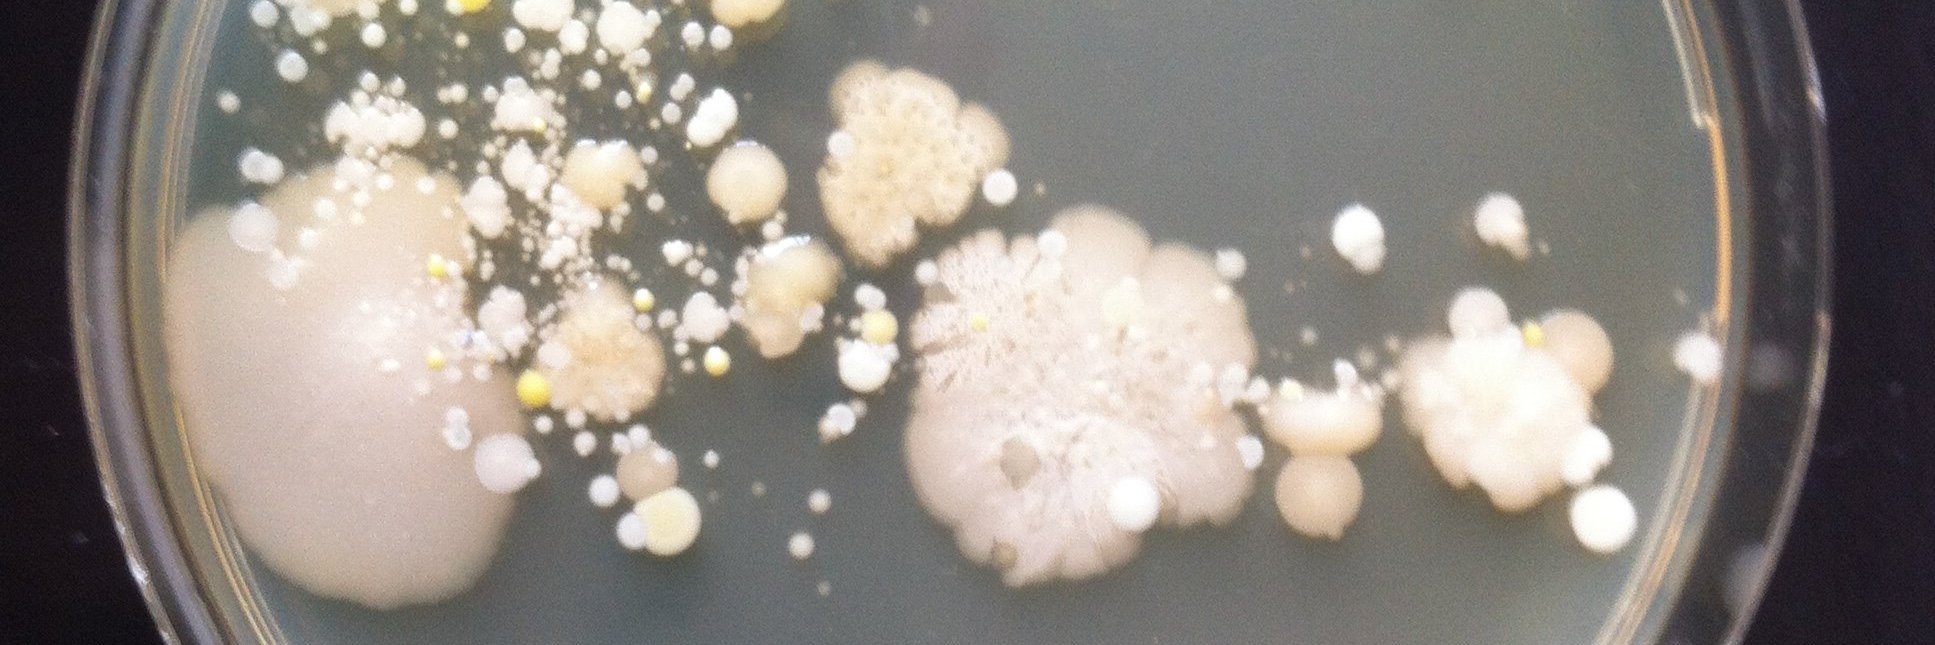
Diana Sousa banner

Diana Sousa
788 posts

Diana Sousa
@SousaDZ
Biological Engineer and microbiologist searching for new anaerobic microorganisms and their networks.



Thank you class 2024 of the #EMBOanaerobic practical course for your enthusiasm and dedication! 5 days of inspiration and hard work have come to an end - hopefully we'll stay in touch!



Apply now for EMBO Practical Course on Breathless Microbes: Life With No Oxygen 08 – 12 July 2024 in Nijmegen, Netherlands meetings.embo.org/event/24-breat… #EMBObreathlessMicrobes

Interested in #anaerobic #microbiology but lack experience to apply it in your research ⁉️Join our @EMBO-funded course in Nijmegen, July 8-12! Learn from experts👩🏫 get hands-on experience👩🔬 and network with peers🍻 Apply now: meetings.embo.org/event/24-breat… #microbiology #research #EMBO

Apply now for EMBO Practical Course on Breathless Microbes: Life With No Oxygen 08 – 12 July 2024 in Nijmegen, Netherlands meetings.embo.org/event/24-breat… #EMBObreathlessMicrobes


Want to do a #PhD focusing on discovery, cultivation and characterization of novel prokaryotes? Come work with us in @MIB_WUR at @WUR! Apply here: wur.nl/en/vacancy/phd… #cultivation #microscopy #archaea #PhDposition Please share & repost

Diender at al reveal the dynamic nature of carboxydotrophic acetogenesis in Clostridium 🧫. Ethanol , once seen as an end product, emerges as a crucial intermediate & co-substrate, optimizing growth in varying CO conditions. ➡️ ami-journals.onlinelibrary.wiley.com/doi/10.1111/17…






The deadline for abstracts submission to the 18th World Congress of Anaerobic Digestion #AD18 in Istambul next year is approaching. Do not miss it.iwa-ad18.org/Docs/IWA18-Cal…





Guillaume comes highly recommended, he has a broad knowledge and expertise in microbiology and genomics, and an innate ability to culture difficult bugs... 👉Hire him!👈






